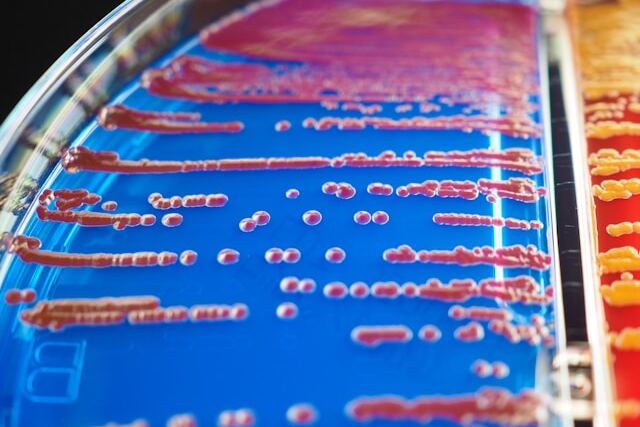

Уходящий 2025 год был насыщен событиями. «Союз Докторов» выделил ключевые события в медицине и науке, которые повлияют и будут значимыми в наступающем году.

Новый тип диабета

Международная федерация диабета сообщила о расширении классификации и выделении диабета 5-го типа. Новый тип диабета связан со снижением секреции инсулина на фоне нормальной чувствительности периферических тканей. Это не аутоиммунный диабет, аутоантитела к островковым клеткам и кетоацидоз отсутствуют.
Вызван недоеданием в детском, подростковом возрасте и нарушением развития тканей поджелудочной железы из-за длительного дефицита питательных веществ.
Позднее экспертная группа сформулировала основные признаки нового заболевания. Частым признаком пятого типа диабета назван индекс массы тела менее 18,5 кг/м2.
Вакцины против рака

Прошедший 2025 год прошел в ожидании российских вакцин против рака. Интерес подстегивали заявления о новой для отечественной фармы мРНК технологии, используемой в вакцинах, и персональный подход. Наконец, в ноябре Минздрав выдал разрешение на введение двух противоопухолевых вакцин.
«Неоонковак» получат пациенты с неоперабельной или метастатической меланомой, «Онкопепт» начнут вводить больным с метастатическим колоректальным раком. Оба препарата персональные для пациента, их изготавливают, используя неоантигены собственной опухоли. Но если «Неоонковак» создан с применением технологии мРНК, «Онкопепт» относится к пептидным вакцинам.
Вакцинация признана четвертым методом профилактики сердечно-сосудистых заболеваний

Европейские кардиологи изменили парадигму профилактики заболеваний сердца и сосудов. Вакцинация стала в 2025 году четвертым основополагающим методом снижения риска сердечно-сосудистых заболеваний, наряду с антигипертензивными, гиполипидемическими и сахароснижающими препаратами.
Помимо профилактики значимых инфекций, вакцины доказанно снижают риск сердечно-сосудистых событий. Пока европейские кардиологи внесли шесть вакцин в перечень рекомендуемых: против гриппа, COVID-19, опоясывающего герпеса, дифтерии и полиомиелита, пневмококковой инфекции и респираторно-синцитиальной инфекции.
Новый принцип лечения гиперхолестеринемии

Национальная липидная ассоциация сформулировала новый принцип лечения гиперхолестеринемии. Чем ниже уровень холестерина ЛПНП, тем лучше. Фактические данные показывают, что даже достижение значений 0,26-1,03 ммоль/л безопасно для пациентов.
Многие исследования указывают на безопасность низких значений ХС-ЛПНП и прогрессивное снижение риска заболеваний сердца и сосудов при снижении атерогенной фракции ниже 30 мг/дл. Доказательств вреда такого снижения не выявлено.
Оценивались в том числе метаболические пути, когда холестерин включен в синтез важных элементов, например, формирование оболочки нервных волокон.
Новая причина болезни Альцгеймера

После многих лет испытаний и неудач в разработках препаратов, фундаментальные исследования основ болезни Альцгеймера уже не фокусируются целиком на бета-амилоиде и тау-белке. Неожиданное открытие, что дефицит лития в мозге может быть ранним этапом болезни Альцгеймера, дает новое направление исследований.
Уровень лития динамически регулируется в мозге, способствуя поддержанию когнитивных функций в процессе старения. При умеренных когнитивных нарушениях, предшествующих болезни Альцгеймера, уровень лития значительно снижается. В экспериментах на животных при исключении металла из рациона питания, вполовину возросло отложение бета-амилоида и накопление тау-белка.
Введение солей лития с пониженным связыванием с амилоидом предотвращало патологические изменения и нарушение памяти у стареющих животных.
Биология старения

Исследования, связанные со старением, набирают обороты. В 2025 году обнаружен связанный со старением клеток белок AP2A1. Исследователи из университета Осаки назвали его потенциальным маркером старения и мишенью для «возрастных» заболеваний. Подавление экспрессии AP2A1 обращает старение вспять, способствуя клеточному омоложению. Под действием ультрафиолета, лекарств его уровень повышается в эпителиальных клетках и фибробластах.
Влияет на старение, сохраняя длину теломер, витамин Д3. Прием 2 тыс. МЕ витамина ежедневно в течение четырех лет предотвращало уменьшение длины теломер на 140 пар оснований. Морские омега-3 жирные кислоты существенно не влияли на показатель.
Грипп и птичий грипп

После завершения пандемии птичий и сезонный грипп опять в центре внимания.
У вируса H5N1 обнаружены мутации, повышающие способность заражать человека. Возбудитель в последние несколько лет вызывает заражение крупного рогатого скота и домашней птицы в США, но известно о 71 случае инфекции у людей и двух случаях смерти за последние четыре года.
В 2025 году зафиксирован первый в мире случай заражения человека вирусом птичьего гриппа H5N5. Он произошел в США при контакте с домашней птицей.
Между тем, прогнозируя летом предстоящий сезон гриппа, Центр им. Гамалеи сообщил об антигенном дрейфе у вируса H3N2, с которым будет связана заболеваемость, что подтверждают данные мониторинга.
В прошедшем году также описана самая крупная серия случаев редкого неврологического осложнения гриппа у детей — энцефалопатии и острой некротизирующей энцефалопатии.
Наконец, реконструированный вирус «испанки» 1918 года российское Правительство внесло в перечень патогенных биологических агентов.
Иммунная система плода
Иммунная система плода ранее считалась практически бездействующей во время беременности, однако новые открытия подтвердили ее становление и активность во втором триместре.
Появляются основные типы клеток врожденного и адаптивного иммунитета. Иммунные клетки плода, особенно Т-клетки, проявляют функциональную «активность», взаимодействуют с созревающими органами, обеспечивая иммунный надзор развивающемуся организму.













